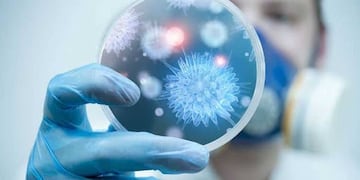

La Universidad Nacional de San Luis fue una de las cuatro universidades del país seleccionadas por el Ministerio de Ciencia, Tecnología e Innovación de la Nación para recibir fondos por 150 mil dólares para instalar un laboratorio de diagnósticos moleculares cuya principal función será dar apoyo y asesoramiento al gobierno provincial, lo que incluye a los ministerios de Salud, Ciencia y Tecnología y a la Secretaría de Medio Ambiente.
Con ese dinero comprarán un ultrafreezer y equipamiento para hacer análisis PCR. Además, la universidad deberá aportar un 30 por ciento de ese valor, para la compra de insumos, pagar los gastos de importación y la refacción y acondicionamiento del lugar donde va a instalar el laboratorio.

Quien coordinó el proyecto, el secretario de Ciencia y Tecnología de la UNSL, Sebastián Andújar, indicó que los fondos fueron cedidos a partir de una invitación realizada por la Nación a través del Programa de Evaluación Institucional. “Participamos en un proyecto para ver cuáles eran las capacidades instaladas durante la época de pandemia y poder fortalecerlas para la pospandemia y fuimos una de las cuatro seleccionadas entre todas las universidades del país” agregó.
Asimismo, el secretario explicó el objetivo general del proyecto. “La creación de esta unidad de desarrollo de herramientas moleculares y la finalidad que tiene es trabajar de forma conjunta con el Gobierno de la Provincia, eso es fundamental. Esto incluirá la continuación de trabajos colaborativos en el Laboratorio de Salud Pública provincial con respecto a la COVID-19, pero también se proyectará a futuro con otro tipo de necesidades, tanto en salud pública, medioambiente, producción, ciencia y técnica, como en otras áreas”.